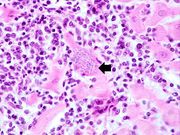

File list
This special page shows all uploaded files.
| Date | Name | Thumbnail | Size | Description | Versions |
|---|---|---|---|---|---|
| 05:24, 21 August 2013 | IPLab12RadiationFibrosis7.jpg (file) |  |
75 KB | This high-power photomicrograph of lung section shows the thickening of the alveolar septum (arrows) by fibrous connective tissue. | 1 |
| 05:24, 21 August 2013 | IPLab12RadiationFibrosis6.jpg (file) |  |
71 KB | This is another high-power photomicrograph of lung section showing the thickening of the alveolar septa (arrows) and accumulations of black anthracotic pigment. | 1 |
| 05:24, 21 August 2013 | IPLab12RadiationFibrosis5.jpg (file) |  |
76 KB | This is a higher-power photomicrograph of lung section. Note the thickening of the alveolar septa (1) and accumulations of anthracotic pigment (2). | 1 |
| 05:23, 21 August 2013 | IPLab12RadiationFibrosis4.jpg (file) |  |
41 KB | This is a low-power photomicrograph of lung section. Note the thickening of the alveolar septa (arrows). | 1 |
| 05:23, 21 August 2013 | IPLab12RadiationFibrosis3.jpg (file) |  |
53 KB | This is a gross photograph showing a closer view of a cut section of lung. An area of fibrosis (arrow) is evident in this photograph. | 1 |
| 05:23, 21 August 2013 | IPLab12RadiationFibrosis2.jpg (file) |  |
27 KB | This is a gross photograph of cut sections of lung. There are several areas of fibrosis (arrows) within the lung parenchyma. | 1 |
| 05:23, 21 August 2013 | IPLab12RadiationFibrosis1.jpg (file) |  |
43 KB | This is a gross photograph of lung demonstrating areas of fibrosis on the pleural surface (arrow). | 1 |
| 05:20, 21 August 2013 | IPLab12Acetaminophen8.jpg (file) |  |
59 KB | This is a higher-power photomicrograph of the skin from this patient showing a blister and the thrombosed small vessels (arrows) in the dermis. | 1 |
| 05:20, 21 August 2013 | IPLab12Acetaminophen7.jpg (file) |  |
40 KB | This low-power photomicrograph of the skin from this patient shows a blister and numerous thrombosed vessels (arrows) in the dermis. | 1 |
| 05:20, 21 August 2013 | IPLab12Acetaminophen6.jpg (file) |  |
32 KB | Photograph taken at autopsy demonstrating the severe necrosis of the skin of foot. | 1 |
| 05:20, 21 August 2013 | IPLab12Acetaminophen5.jpg (file) |  |
71 KB | This is a high-power photomicrograph of the edge of the necrosis. Again, note the coagulation necrosis and hemorrhage in this area. The viable hepatocytes at the edge of this necrosis are vacuolated (arrows). | 1 |
| 05:19, 21 August 2013 | IPLab12Acetaminophen4.jpg (file) |  |
95 KB | This is a medium-power photomicrograph of the areas of hemorrhagic necrosis. Note the coagulation necrosis and hemorrhage in this area. Viable hepatocytes can be seen along the edge of this lesion. | 1 |
| 05:19, 21 August 2013 | IPLab12Acetaminophen3.jpg (file) |  |
100 KB | This is another example of the areas of hemorrhagic necrosis (arrows). | 1 |
| 05:19, 21 August 2013 | IPLab12Acetaminophen2.jpg (file) |  |
103 KB | In this photomicrograph of the liver from this patient there are areas of hemorrhagic necrosis (arrows). | 1 |
| 05:19, 21 August 2013 | IPLab12Acetaminophen1.jpg (file) |  |
48 KB | This gross photograph of the liver from this patient demonstrates the pale areas of necrosis (arrows). | 1 |
| 05:17, 21 August 2013 | IPLab12Alcoholic14.jpg (file) |  |
30 KB | This is another photograph of the cerebellum from this patient demonstrating the marked thinning of the anterior portion of the cerebellum (arrows). This pattern of cerebellar damage is consistent with Wernicke's encephalopathy. | 1 |
| 05:16, 21 August 2013 | IPLab12Alcoholic13.jpg (file) |  |
41 KB | This photograph of the cerebellum from this patient demonstrates the marked thinning of the anterior portion of the cerebellum (arrows). | 1 |
| 05:16, 21 August 2013 | IPLab12Alcoholic12.jpg (file) |  |
82 KB | This photomicrograph shows the dilated vessel just under the epithelium of the esophagus. | 1 |
| 05:16, 21 August 2013 | IPLab12Alcoholic11.jpg (file) |  |
58 KB | This photograph taken from still another patient at autopsy demonstrates the esophageal varices in the distal esophagus (arrows). The esophagus was clamped before removing the esophagus from the body in order to trap the blood in these distended varice... | 1 |
| 05:16, 21 August 2013 | IPLab12Alcoholic10.jpg (file) |  |
105 KB | This is a photograph taken from another patient at autopsy to demonstrate numerous esophageal varices in the distal esophagus (arrows). None of these varices have ruptured. | 1 |
| 05:15, 21 August 2013 | IPLab12Alcoholic9.jpg (file) |  |
41 KB | In this closer view of the distal esophagus the ruptured varix is indicated by the probe. Other varices and areas of submucosal hemorrhage can also be appreciated. | 1 |
| 05:15, 21 August 2013 | IPLab12Alcoholic8.jpg (file) |  |
57 KB | This photograph taken at autopsy shows the distal portion of the esophagus and the stomach. The esophageal varices are visible just under the mucosa of the esophagus (arrows). Some of the blood from the ruptured varix can still be seen in the stomach. | 1 |
| 05:15, 21 August 2013 | IPLab12Alcoholic7.jpg (file) |  |
32 KB | This photograph was taken during the EGD while the patient was alive. Note the red hyperemic areas (1) and the area of hemorrhage (2). | 1 |
| 05:14, 21 August 2013 | IPLab12Alcoholic5.jpg (file) |  |
122 KB | In this high-power photomicrograph of trichrome-stained liver, the bands of fibrous tissue surround the hepatocyte nodules. There is some degeneration and dropout of hepatocytes in this nodule. Also note the increased numbers of bile ducts in the triad... | 1 |
| 05:13, 21 August 2013 | IPLab12Alcoholic6.jpg (file) |  |
42 KB | In this high-power photomicrograph of trichrome-stained liver, the bands of fibrous tissue surround the hepatocyte nodules. There is some degeneration and dropout of hepatocytes in this nodule. Also note the increased numbers of bile ducts in the triad... | 1 |
| 05:13, 21 August 2013 | IPLab12Alcoholic4.jpg (file) |  |
130 KB | In this is medium-power photomicrograph of trichrome stained liver the bands of fibrous tissue are seen to form "bridges" between triad areas (arrows); this is called "bridging fibrosis." Also note the fibrous tissue (arrows) and how the hepatocytes ar... | 1 |
| 05:13, 21 August 2013 | IPLab12Alcoholic3.jpg (file) |  |
102 KB | This is a low-power photomicrograph of this liver stained with a trichrome stain to highlight the fibrous tissue (arrows). Also note the nodular pattern. | 1 |
| 05:13, 21 August 2013 | IPLab12Alcoholic2.jpg (file) |  |
65 KB | This is a closer view of the liver from this patient. Again note the nodular pattern and the areas of greenish discoloration. These green nodules are actually the viable hepatocytes that are stained green because of bile stasis. The pale areas are the ... | 1 |
| 05:13, 21 August 2013 | IPLab12Alcoholic1.jpg (file) |  |
40 KB | This is a gross photograph of the liver from this patient. Note the nodular pattern and the areas of greenish discoloration as well as pale tan areas. | 1 |
| 05:08, 21 August 2013 | IPLab11Chagas6.jpg (file) |  |
34 KB | This is a higher-power photomicrograph of an H & E stained heart biopsy from this patient. Note the T. cruzi amastigotes (arrows) within this longitudinal section of a myocyte. | 1 |
| 05:08, 21 August 2013 | IPLab11Chagas5.jpg (file) |  |
48 KB | This is a higher-power photomicrograph of an H & E stained heart biopsy from this patient. At this magnification the organisms within a myocyte (arrows) and the adjacent inflammatory response are more clearly seen. The individual organisms within the m... | 1 |
| 05:07, 21 August 2013 | IPLab11Chagas4.jpg (file) | |
63 KB | This is a higher-power photomicrograph of an H & E stained heart biopsy from this patient. Again, note the organisms within a myocyte (arrow) and the inflammatory response. | 1 |
| 05:07, 21 August 2013 | IPLab11Chagas3.jpg (file) |  |
64 KB | This is a low-power photomicrograph of an H & E stained section from the heart biopsy of this patient. Note the organisms within a myocyte (arrow) and the adjacent inflammatory response. | 1 |
| 05:07, 21 August 2013 | IPLab11Chagas2.jpg (file) |  |
34 KB | This peripheral blood smear from the patient shows a higher power view of a Trypanosoma cruzi trypomastigote. Note the prominent kinetoplast (arrow). | 1 |
| 05:07, 21 August 2013 | IPLab11Chagas1.jpg (file) |  |
37 KB | This peripheral blood smear from the patient shows two trypomastigotes of Trypanosoma cruzi. | 1 |
| 05:05, 21 August 2013 | IPLab11Schistosomiasis3.jpg (file) |  |
79 KB | This is a photomicrograph of the liver from another patient with Schistosoma mansoni. These eggs have elicited a robust inflammatory response, including a multinucleated giant cell. These lesions go on to heal by fibrosis resulting in cirrhosis and the... | 1 |
| 05:05, 21 August 2013 | IPLab11Schistosomiasis2.jpg (file) |  |
41 KB | This is high-power photomicrograph of the patient's fecal specimen containing another Schistosoma mansoni egg. | 1 |
| 05:05, 21 August 2013 | IPLab11Schistosomiasis1.jpg (file) |  |
53 KB | This is a high-power photomicrograph of the patient's fecal specimen containing the characteristic egg of Schistosoma mansoni. Note the spine on the egg (arrow). | 1 |
| 05:04, 21 August 2013 | IPLab11Cysticercosis4.jpg (file) |  |
13 KB | This is a photograph of the body of an adult tapeworm. Note the body segments. | 1 |
| 05:04, 21 August 2013 | IPLab11Cysticercosis3.jpg (file) |  |
46 KB | This photograph of an autopsy specimen from another patient shows an adult tapeworm in the intestine. Note that the worm attaches to the luminal surface of the intestine via the scolex. | 1 |
| 05:03, 21 August 2013 | IPLab11Cysticercosis2.jpg (file) |  |
20 KB | This is a photograph of the cyst that was surgically removed. The cyst is filled with a clear fluid and contains a scolex. | 1 |
| 05:03, 21 August 2013 | IPLab11Cysticercosis1.jpg (file) |  |
17 KB | This is a head CT showing the two cysts (arrows). | 1 |
| 05:02, 21 August 2013 | IPLab11Ascariasis7.jpg (file) |  |
40 KB | This high-power photomicrograph of the fecal specimen from this patient shows a Giardia lamblia cyst (arrow). | 1 |
| 05:01, 21 August 2013 | IPLab11Ascariasis6.jpg (file) |  |
29 KB | This high-power photomicrograph of the fecal specimen from this patient shows a Giardia lamblia trophozoite. Note the two nuclei and the tapered end (that goes out of the plane of focus) containing flagella (arrow). | 1 |
| 05:01, 21 August 2013 | IPLab11Ascariasis5.jpg (file) |  |
41 KB | This high-power photomicrograph of the fecal specimen from this same patient shows an Entamoeba histolytica cyst (arrow). | 1 |
| 05:01, 21 August 2013 | IPLab11Ascariasis4.jpg (file) |  |
22 KB | This is a higher-power photomicrograph of another ascarid egg. | 1 |
| 05:01, 21 August 2013 | IPLab11Ascariasis3.jpg (file) |  |
19 KB | This is a high-power photomicrograph of a fecal specimen from this patient showing an ascarid egg (arrow). | 1 |
| 05:01, 21 August 2013 | IPLab11Ascariasis2.jpg (file) |  |
16 KB | This is a photograph of an autopsy specimen from another case of ascariasis. The adult ascarid (arrow) can be seen in the section of small bowel from this patient. | 1 |
| 05:00, 21 August 2013 | IPLab11Ascariasis1.jpg (file) |  |
45 KB | This is a photograph of an adult ascarid like the ones removed from the small bowel of this patient. | 1 |
| 04:58, 21 August 2013 | IPLab11Leishmaniasis6.jpg (file) |  |
19 KB | This is a high-power photomicrograph of a touch prep made from the skin lesion at the time of biopsy. A single macrophage can be seen with intracytoplasmic leishmania organisms (arrows). | 1 |